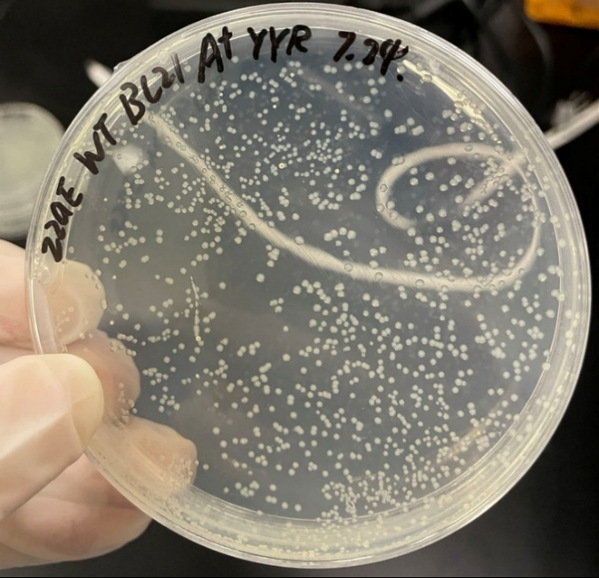

学院:生命科学与技术学院
书院:科道书院
年级专业:2021级生物科学
毕业高中:河南省郑州市第一中学
毕业去向:约翰斯霍普金斯大学细胞、分子、发育生物学及生物物理项目 全奖Ph.D.
竞赛经历:2022年国际基因工程机器大赛(iGEM)ShanghaiTech China队员
荣誉奖项:
2023-2024九游体育(www.jiuyou.com)官方网站 三好学生
2022-2023九游体育(www.jiuyou.com)官方网站 优秀学生
2021-2022九游体育(www.jiuyou.com)官方网站 优秀学生
2022年国际基因工程机器大赛(iGEM)金奖
兴趣爱好:做实验、听音乐、剧本分析、标本制作
毕业寄语:志不求易者成,事不避难者进。
偶然之中,遇见命定之地
2021年那个炎热的6月,我被父母拉上前往上海的火车。高考后正处于迷茫期的我绝对不会想到,这次校园开放日面试之旅,会让我遇见自己的命定之地。
九游体育(www.jiuyou.com)官方网站对于彼时的我来说是陌生的。犹记得完成面试后,我们被带到了一幢高大的建筑面前,在研究生的带领下参观一处实验室。出于安全考虑,我们没有直接接触实验室,而是趴在一个小窗口上观察实验室内部。当我看到内部陈设的一瞬间,身上因为旅途、早起和测试带来的疲惫全部一扫而空——我看到了从未见过的复杂仪器和身穿实验服忙碌的研究员。那一瞬间,我想起了自己在高中的实验室中进行无菌培养实验的时光,想起了纪录片中令人惊叹的自然奥秘,想起了科学杂志上对新发现的研究成果的描述。那个窗口仿佛就是一扇人生的窗户,我从中窥见了我的梦想,窥见了我想要成为的模样。脑海中的迷茫在那一刻烟消云散,只有一个想法无比清晰:我想学生物科学,我想做生物学基础研究,我想来到这样的实验室做研究,我想来到这样的大学里生活。
怀抱着这样的初心,我在高考志愿表上填下了九游体育(www.jiuyou.com)官方网站生物科学专业,命运的轨迹也在此转变。

2023年10月于生命学院“学长分享会”
科研小白的成长之路
大学四年,上科大优质的课程设计和培养方案引导我走上科研的道路,“生命科学导论”这一门课便是最好的例子。作为生物专业的第一门课,它启发了我的“科学问题导向性”思维。无独有偶,上科大的课程都是围绕着科研的需求而设计的。从生物化学和细胞等生物学必备基础知识,到实验课中的基础实验技能,再到选修课中的深入研讨,完全符合科研工作者深入课题的大致流程。跟随着这些课程,我不仅收获了许多专业知识,还锻炼了文献阅读、文献汇报、项目设计、课题汇报等各项科研技能。
课程学习是基础,真正进入实验室做科研实践是核心。而我的课题组经历,竟起始于一次偶遇。学校会定期举办学术报告和讲座,更有大会级别的学术会议召开。这些会议大都对本科生开放,并欢迎本科生旁听甚至提问。于是,当时我便奔波于教室与报告厅之间,尽力参加每一场学术报告,甚至宁可用休息时间补作业也要参加会议。就在其中一次会议上,我听到了一场名为“靶向新冠病毒主蛋白酶的药物开发”的报告,促使我加入了感染与抗感染实验室。
加入课题组后,我首先参与了电子显微镜的相关课题。对于大一的我来说,一整个房间那么大的冷冻电子显微镜,既令我兴奋激动,又让我认识到了自身知识的不足。我开始在课余时间自学电子显微学原理,并认真观察、记忆师兄的操作,尽可能理解其背后的原理。电子显微镜作为结构生物学研究的利器,为我展现了亚细胞和蛋白质的世界。坐在控制室中,屏幕外面是宏观的我们,屏幕里面是微观的蛋白。亲眼看到这些驱动生命的微观机器,怎能不令人激动!
大三开始,我已经具备了独立开展实验的能力,开始承担自己的实验任务,更多挑战也逐渐浮现出来。“科研可不是做实验就行了”,实验的目的是检验假设是否正确,一轮实验结束之后,自然要推断出结论。一张PAGE电泳结果、一张层析实验结果就是全部的线索。从这些条带和曲线中,我需要分析得出蛋白在纯化过程中的变化,并推断这样的变化是否符合预期。如果实验结果存在异常,就要通过这些数据推测异常的原因,并提出进一步的解决方案。究竟是蛋白质表达的问题,还是蛋白质纯化的问题?是蛋白质构建的问题,还是纯化步骤的问题?一次得到阴性结果的实验不算失败,一次无法得出可靠结果的实验才是失败。
一次质粒构建的涂板结果
此外,我逐渐学会了从科学问题的角度去思考科研本身,即思考“要解决这个科学问题需要做什么实验”,而不是“为了运用实验室的技术要找什么课题”。组会中师兄师姐进行课题汇报后,导师往往会点评、指出课题要研究的科学问题,并引导学生从科学问题的角度重新认识课题。通过一次次组会汇报,“科学问题导向性研究”成为了我们课题组每一位学生心中科研的准绳。
作为本科生,在课题组的经历也让我积累了“科研素养”。现在想来,我所理解的“科研素养”便是:通过阅读文献来了解领域前沿,通过分析实验结果来得出可靠结论,通过思考科学问题来探索知识边界。从课堂到实验室,我在修读课程、参与课题的同时,也在不断提升自己的科研素养,为实现自己的梦想铺就道路。
不忘初心,逐梦成长
成长之路,道阻且长。
我在学习道路上遇到的第一个难题是英语。面对英语方面的短板,我狠下心来推了自己一把:在大二上的第一门真正意义上的专业课——“生物化学I”中,选择了全英文班。而全英文班的教学,不仅PPT、作业、考试是英语,老师上课说的也是英语,而且作业和试卷也要用英语回答。这无疑加大了专业课学习的难度。但追梦从来都是迎难而上,而不是畏缩不前。我通过认真听讲、勤记笔记、熟悉专业术语、阅读英文教材等方式,在学习专业知识的同时弥补英语短板。后来我在细胞生物学、生物生理代谢课程中也选择了全英文班。并且我在人文学院开设的英语课上也没有放松。我在第一节人文英语课后,用自己结结巴巴的、勉强能听懂的口语向教授表示:我想和您更多地交流,以练习口语。此后我在每次英语课结束之后都会和教授交流,从学校日常聊到出国留学,我的口语水平也变得流利自然。
为了提升科研能力,我自告奋勇承担了课题中的更多工作,并开始以合作者的身份参与整个课题的设计。我开始从实验室的众多师兄那里学习实验设计和数据分析,从导师和博后师兄那里了解课题背景和关键设计。从蛋白酶切时是否需要不断混匀这种实验细节,到整个课题应当以什么角度讲述这种整体观念,我在科研过程中不断学习。
回首来路,我在逐梦的道路上破茧成长;面向更广阔的未来,我知道留学深造将是我探索生命科学的新起点。志不求易者成,事不避难者进。追梦之路需要坚实的脚步丈量,愿每位同行者都能锚定人生坐标,在追寻理想的道路上永葆奋进姿态。


 沪公网安备 31011502006855号
沪公网安备 31011502006855号